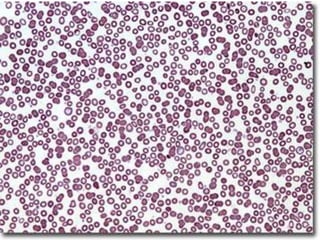

Iron deficiency anemia is the most common type of anemia globally. It results from inadequate iron intake or absorption to meet physiological needs. Common symptoms include pallor, weakness, and fatigue. Diagnosis involves blood tests showing microcytic hypochromic anemia, low serum iron and ferritin levels, and high total iron binding capacity. Treatment consists of oral iron supplementation in the form of ferrous salts to replenish iron stores.
![Anemia, Iron deficiency anemia
Dr. Kalpana Malla
MD Pediatrics
Manipal Teaching Hospital
Download more documents and slide shows on The Medical Post [ www.themedicalpost.net ]](https://image.slidesharecdn.com/hematology-anemiaida-120108092913-phpapp01/75/Iron-deficiency-anemia-1-2048.jpg)

![Thank you
Download more documents and slide shows on The
Medical Post [ www.themedicalpost.net ]](https://image.slidesharecdn.com/hematology-anemiaida-120108092913-phpapp01/85/Iron-deficiency-anemia-47-320.jpg)